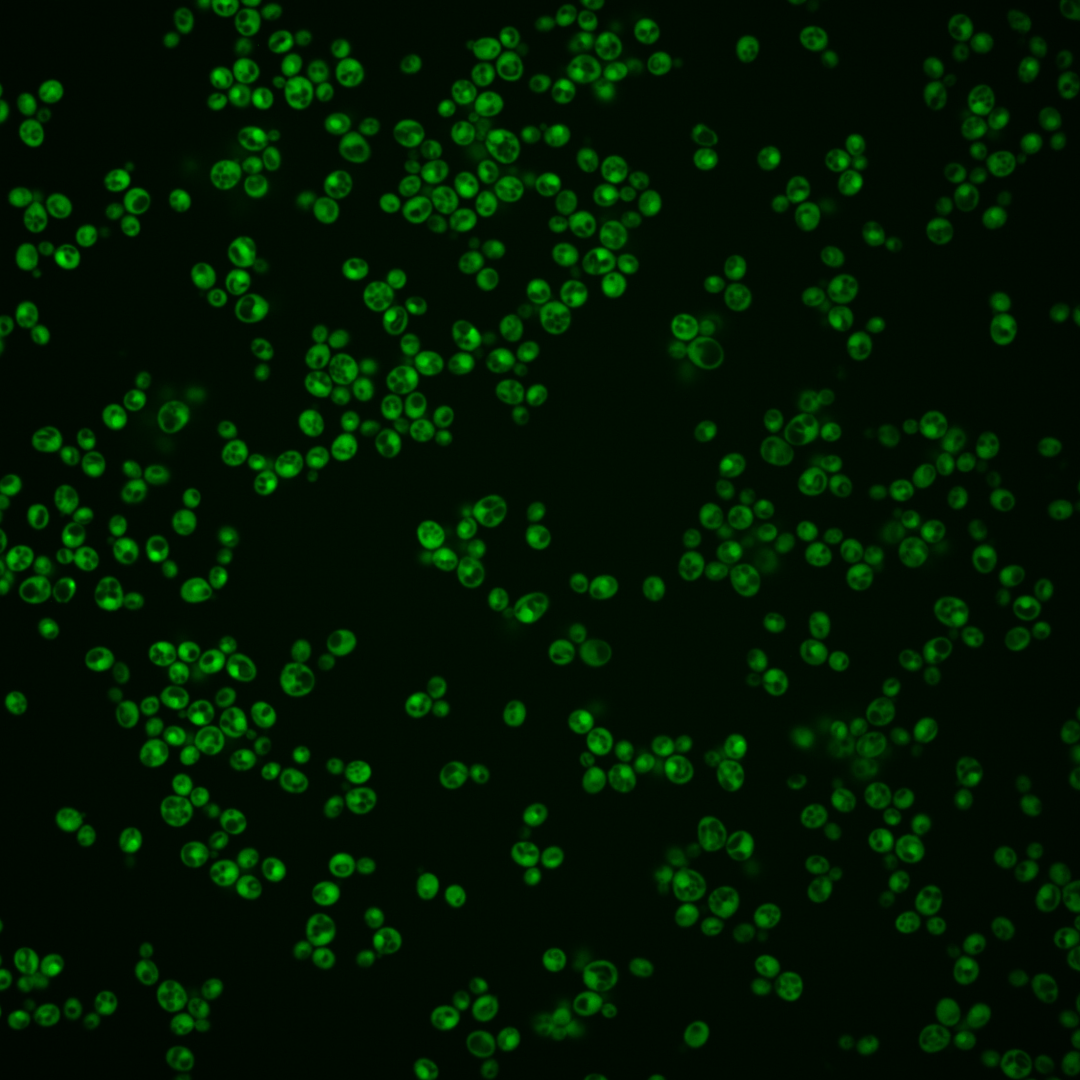
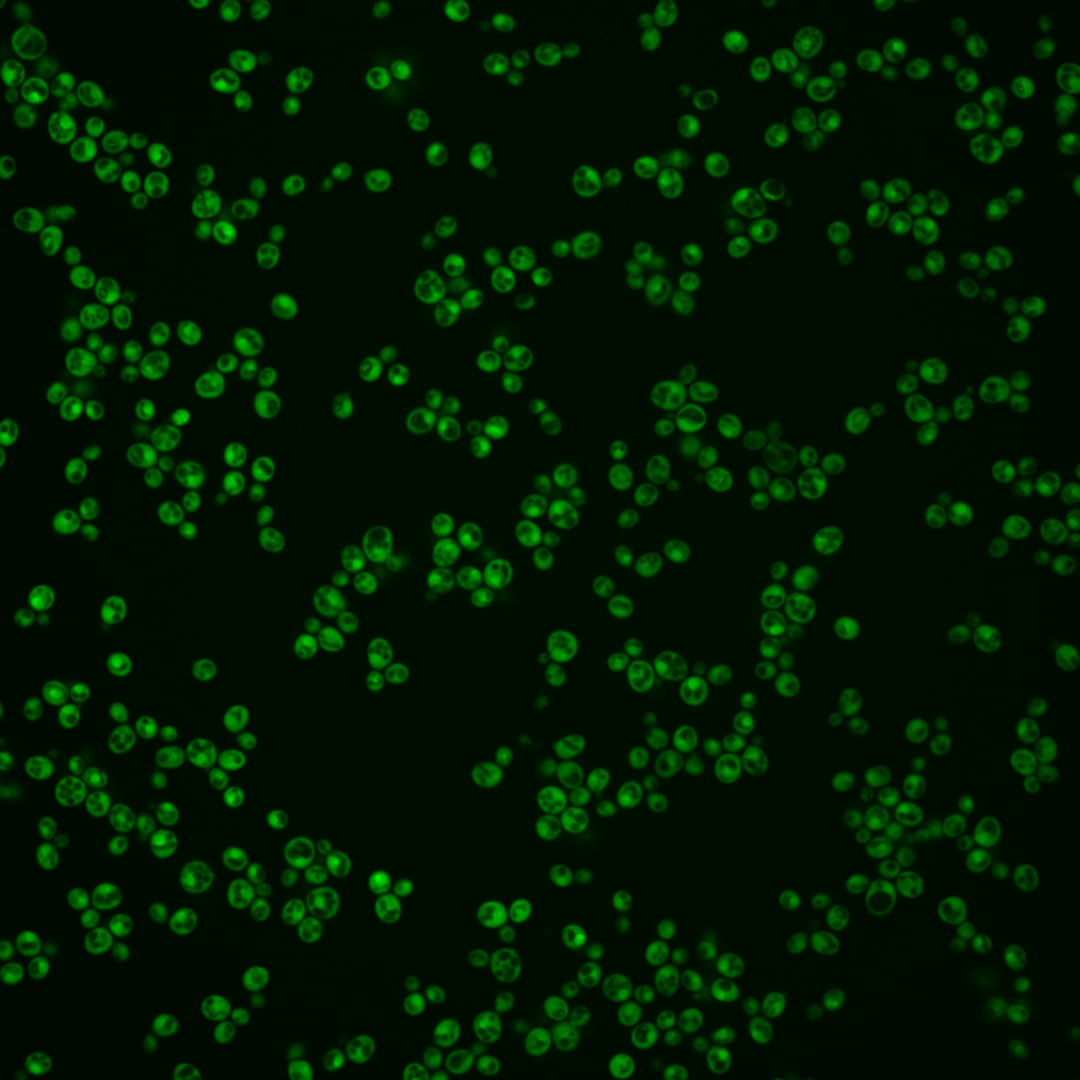
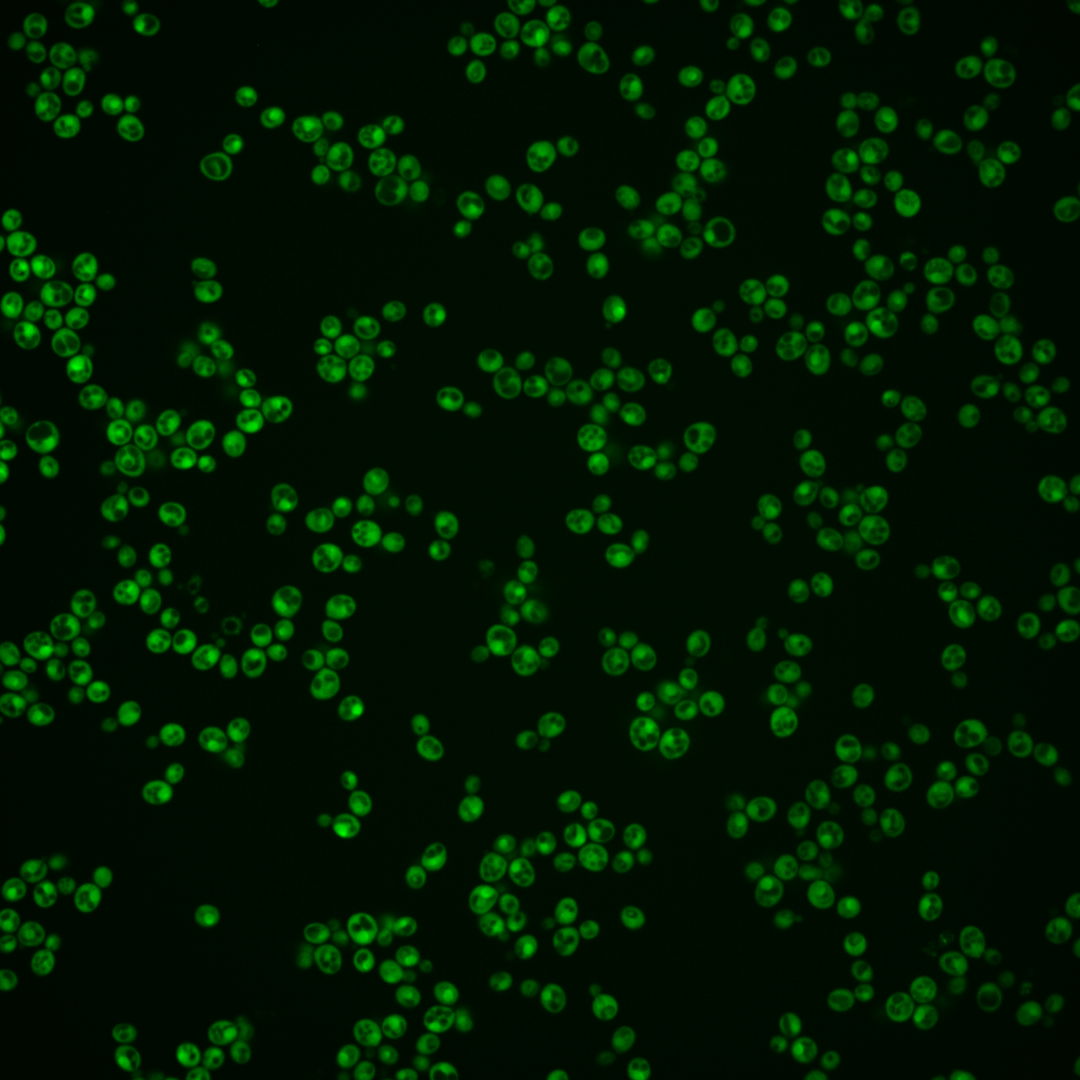
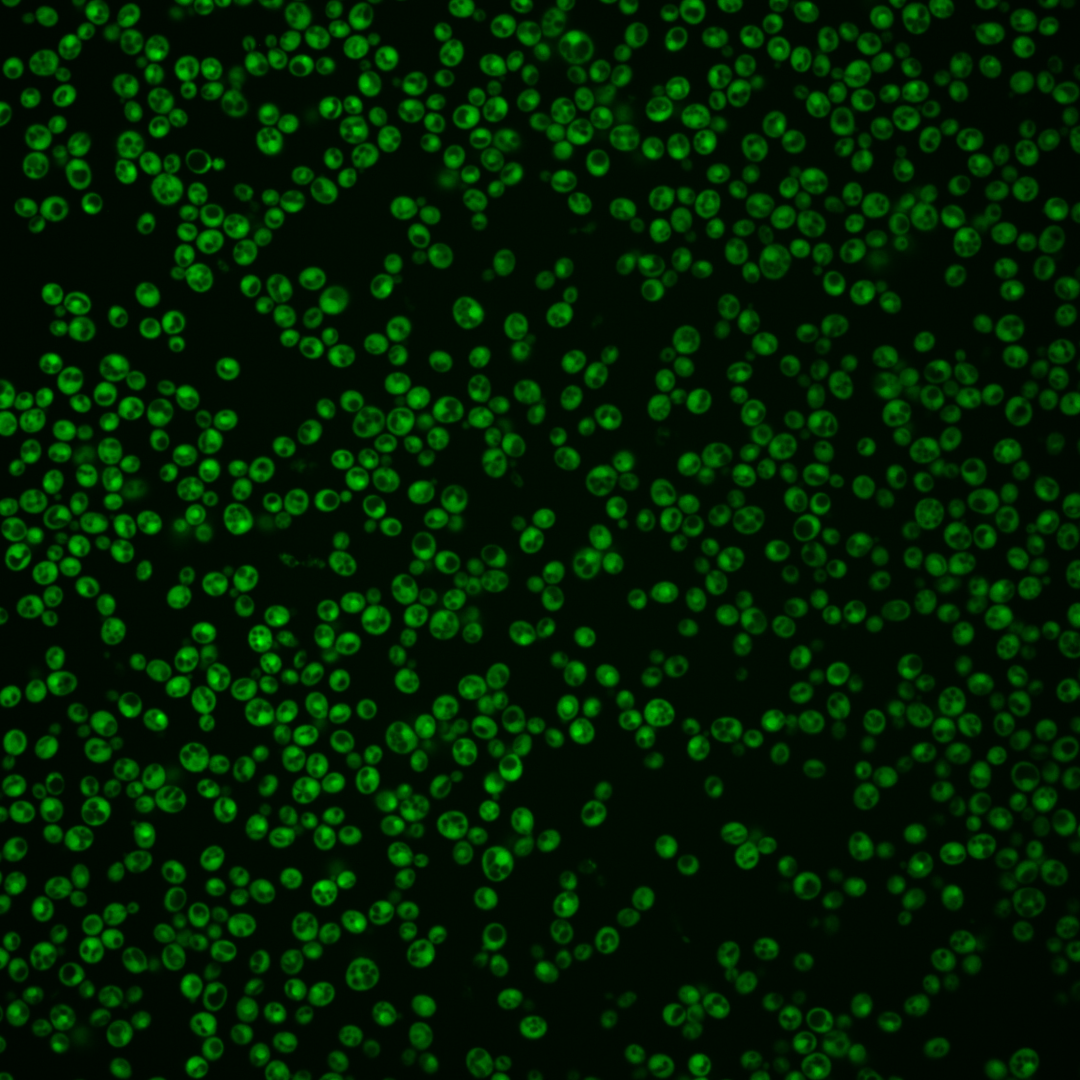
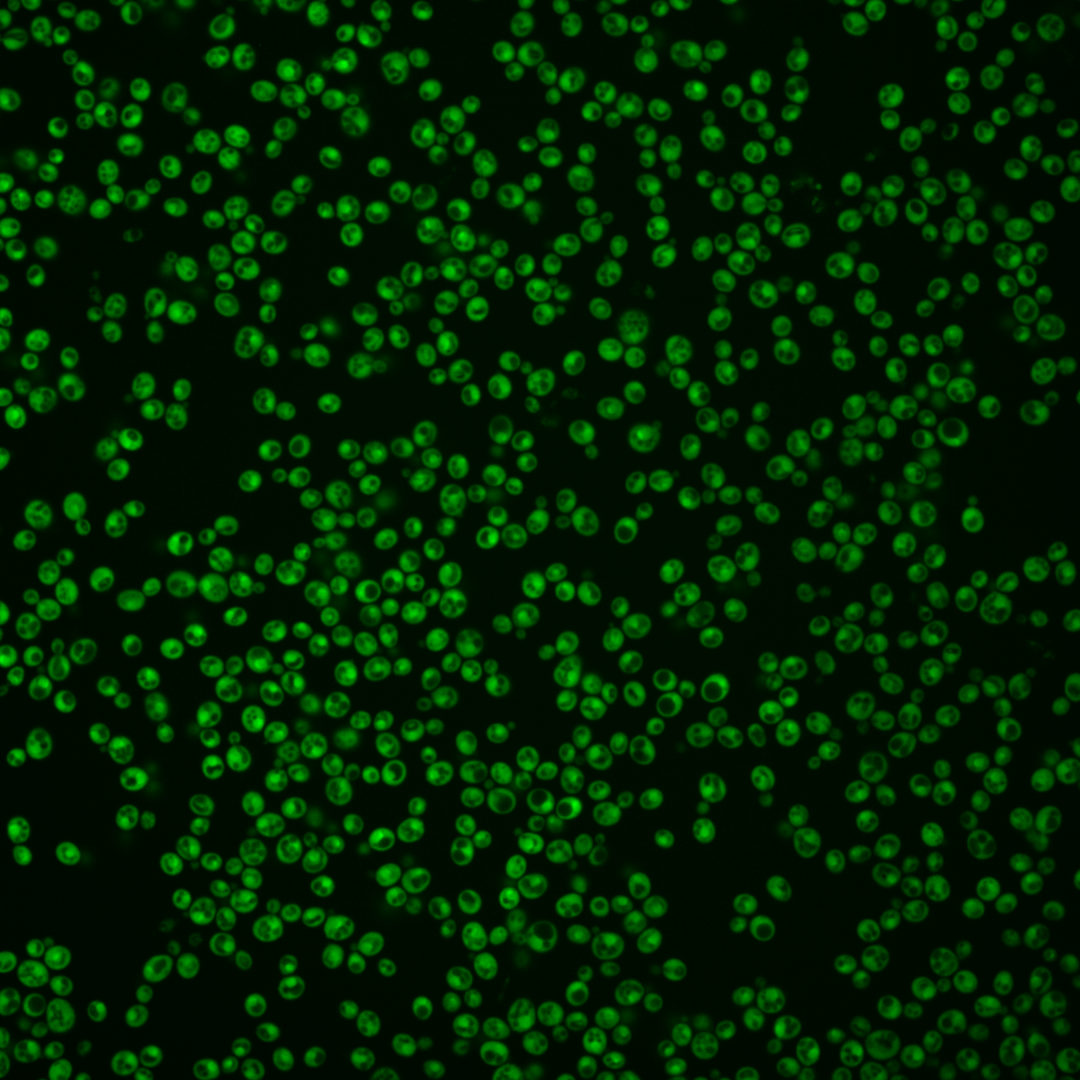
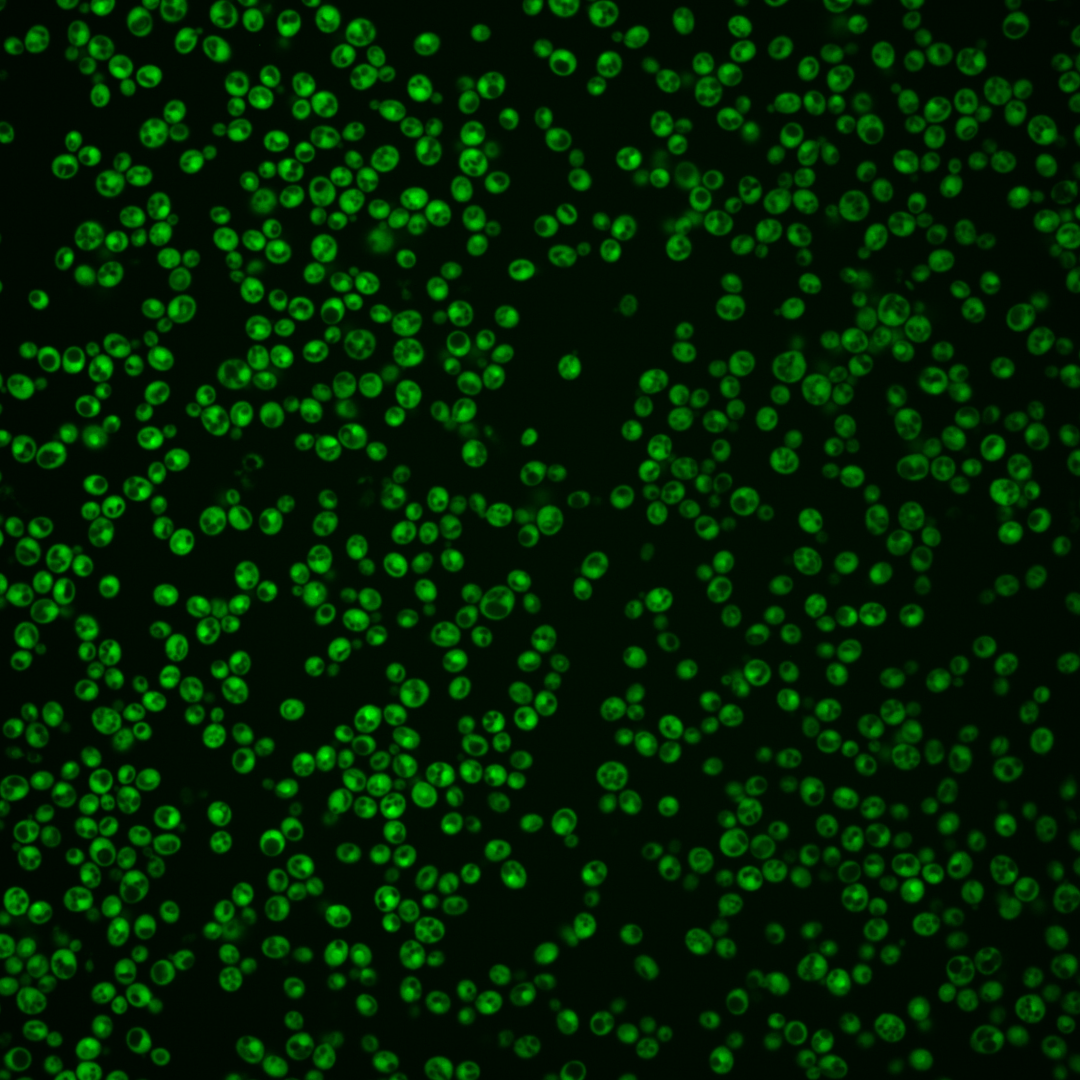
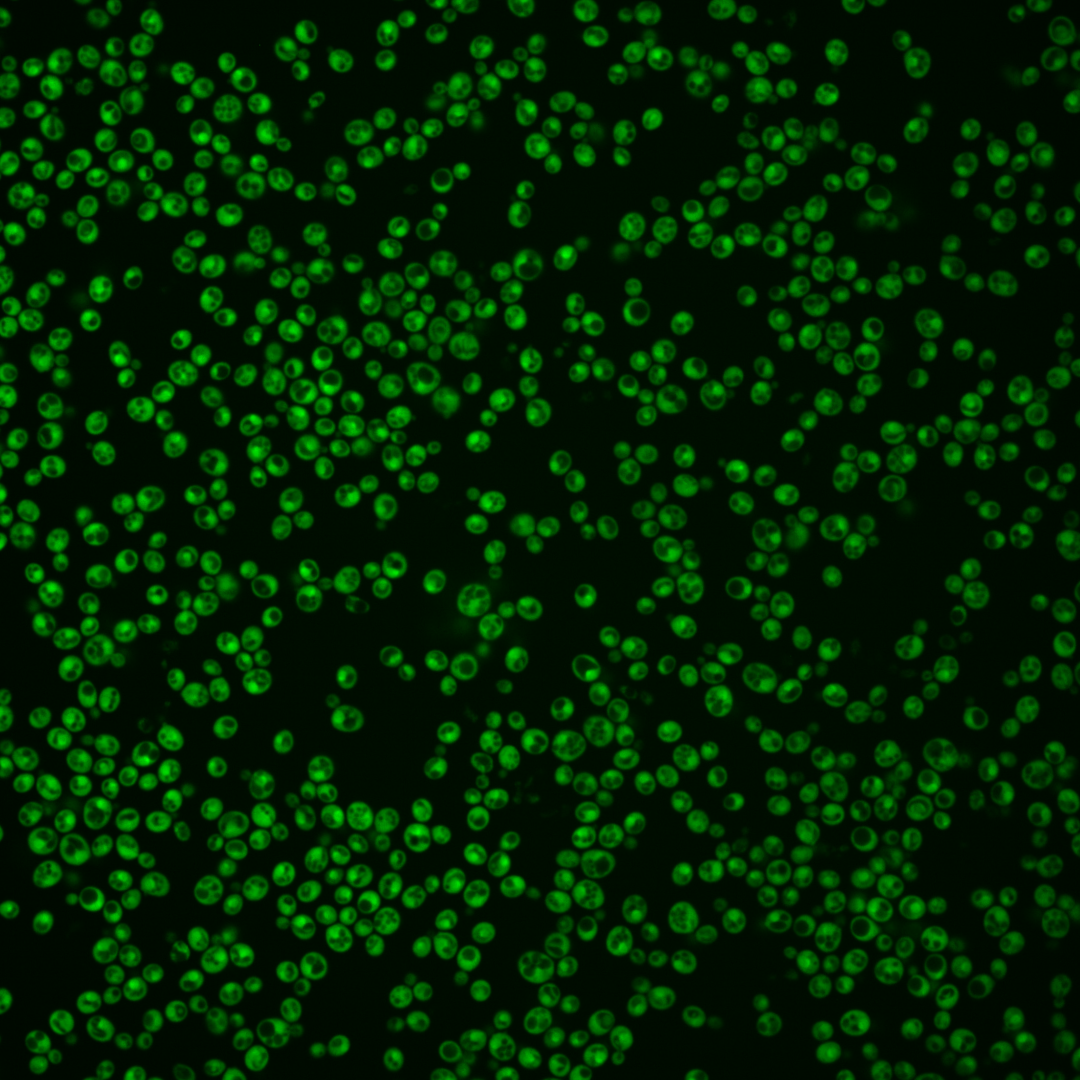

| Standard name | |
|---|---|
| Human Ortholog | |
| Description | Methionine aminopeptidase; catalyzes the cotranslational removal of N-terminal methionine from nascent polypeptides; function is partially redundant with that of Map2p |
Micrographs




















































































Sub-cellular Localization
Yeast GFP Assignment
Protein Abundance
Localization Change
External localization resources
| ensLOC | DeepLoc | |||||||||||||||||||||||
|---|---|---|---|---|---|---|---|---|---|---|---|---|---|---|---|---|---|---|---|---|---|---|---|---|
| Localization | WT1 | WT2 | WT3 | RAP60 | RAP140 | RAP220 | RAP300 | RAP380 | RAP460 | RAP540 | RAP620 | RAP700 | HU80 | HU120 | HU160 | rpd3Δ_1 | rpd3Δ_2 | rpd3Δ_3 | WT1 | WT2 | WT3 | AF100 | AF140 | AF180 |
| Cortical Patches | 0 | 0 | 0 | 0 | 2 | 0 | 1 | 3 | 0 | 0 | 0 | 0 | 0 | 0 | 0 | 0 | 0 | 0 | 0 | 0 | 0 | 0 | 0 | 0 |
| Bud | 0 | 0 | 0 | 0 | 0 | 0 | 4 | 0 | 0 | 3 | 4 | 5 | 0 | 0 | 0 | 0 | 1 | 0 | 1 | 1 | 1 | 1 | 5 | 4 |
| Bud Neck | 0 | 0 | 0 | 0 | 0 | 0 | 0 | 0 | 0 | 0 | 0 | 0 | 0 | 0 | 0 | 0 | 0 | 0 | 0 | 0 | 0 | 0 | 0 | 0 |
| Bud Site | 0 | 0 | 0 | 0 | 0 | 0 | 0 | 1 | 0 | 1 | 1 | 0 | 0 | 0 | 0 | 0 | 0 | 0 | – | – | – | – | – | – |
| Cell Periphery | 0 | 0 | 0 | 1 | 1 | 2 | 1 | 2 | 0 | 3 | 1 | 1 | 0 | 1 | 1 | 0 | 1 | 0 | 0 | 0 | 0 | 0 | 0 | 0 |
| Cytoplasm | 126 | 84 | 204 | 175 | 151 | 200 | 156 | 102 | 62 | 45 | 30 | 56 | 239 | 414 | 356 | 21 | 56 | 30 | 97 | 63 | 174 | 155 | 367 | 293 |
| Endoplasmic Reticulum | 1 | 0 | 3 | 3 | 2 | 4 | 2 | 2 | 0 | 1 | 2 | 2 | 3 | 1 | 2 | 1 | 5 | 2 | 2 | 0 | 7 | 0 | 5 | 2 |
| Endosome | 0 | 0 | 2 | 0 | 2 | 2 | 3 | 12 | 5 | 4 | 2 | 0 | 0 | 0 | 0 | 0 | 1 | 1 | 0 | 0 | 6 | 1 | 7 | 7 |
| Golgi | 1 | 1 | 7 | 15 | 15 | 4 | 3 | 7 | 1 | 2 | 0 | 0 | 6 | 11 | 25 | 1 | 3 | 2 | 0 | 0 | 0 | 0 | 0 | 0 |
| Mitochondria | 1 | 0 | 1 | 0 | 3 | 14 | 46 | 37 | 35 | 109 | 60 | 71 | 0 | 0 | 0 | 0 | 0 | 0 | 0 | 0 | 1 | 0 | 0 | 0 |
| Nucleus | 0 | 0 | 4 | 0 | 3 | 16 | 43 | 74 | 23 | 41 | 26 | 33 | 2 | 1 | 3 | 0 | 0 | 0 | 30 | 31 | 19 | 25 | 58 | 46 |
| Nuclear Periphery | 0 | 0 | 0 | 0 | 0 | 0 | 0 | 0 | 0 | 0 | 0 | 0 | 0 | 0 | 0 | 0 | 0 | 0 | 1 | 0 | 6 | 0 | 9 | 9 |
| Nucleolus | 0 | 0 | 0 | 1 | 3 | 4 | 5 | 10 | 3 | 3 | 1 | 2 | 0 | 0 | 2 | 0 | 1 | 2 | 0 | 0 | 1 | 0 | 2 | 1 |
| Peroxisomes | 0 | 0 | 0 | 0 | 0 | 0 | 0 | 0 | 0 | 0 | 0 | 0 | 0 | 0 | 0 | 0 | 0 | 0 | 0 | 0 | 0 | 0 | 0 | 0 |
| SpindlePole | 0 | 0 | 0 | 0 | 0 | 0 | 0 | 0 | 0 | 0 | 0 | 0 | 0 | 0 | 0 | 0 | 0 | 0 | 0 | 0 | 2 | 0 | 6 | 5 |
| Vac/Vac Membrane | 13 | 9 | 49 | 26 | 58 | 73 | 165 | 225 | 107 | 148 | 103 | 106 | 38 | 84 | 150 | 6 | 27 | 12 | 6 | 9 | 20 | 17 | 34 | 39 |
| Unique Cell Count | 136 | 91 | 240 | 200 | 207 | 282 | 374 | 410 | 216 | 303 | 199 | 232 | 267 | 461 | 448 | 24 | 72 | 37 | 144 | 109 | 250 | 206 | 501 | 416 |
| Labelled Cell Count | 142 | 94 | 270 | 221 | 240 | 319 | 429 | 475 | 236 | 360 | 230 | 276 | 288 | 512 | 539 | 29 | 95 | 49 | 144 | 109 | 250 | 206 | 501 | 416 |
Yeast GFP Assignment
Protein Abundance
| Screen | WT1 | WT2 | WT3 | RAP60 | RAP140 | RAP220 | RAP300 | RAP380 | RAP460 | RAP540 | RAP620 | RAP700 | HU80 | HU120 | HU160 | rpd3Δ_1 | rpd3Δ_2 | rpd3Δ_3 | AF100 | AF140 | AF180 |
|---|---|---|---|---|---|---|---|---|---|---|---|---|---|---|---|---|---|---|---|---|---|
| Mean Cell GFP Intensity (1e-4) | 21.0 | 32.5 | 22.8 | 22.7 | 18.2 | 14.5 | 12.5 | 12.3 | 10.8 | 9.7 | 9.2 | 9.3 | 28.9 | 28.0 | 25.9 | 30.8 | 31.8 | 34.2 | 28.7 | 30.0 | 31.0 |
| Std Deviation (1e-4) | 4.9 | 5.8 | 5.4 | 4.0 | 4.1 | 3.2 | 3.3 | 3.6 | 2.6 | 2.9 | 2.4 | 3.0 | 6.1 | 5.8 | 5.8 | 12.7 | 9.4 | 11.4 | 6.5 | 6.2 | 6.5 |
| Intensity Change (Log2) | – | – | – | -0.01 | -0.33 | -0.65 | -0.86 | -0.89 | -1.08 | -1.23 | -1.32 | -1.29 | 0.34 | 0.3 | 0.19 | 0.43 | 0.48 | 0.59 | 0.34 | 0.4 | 0.45 |
Localization Change
| Localization | RAP60 | RAP140 | RAP220 | RAP300 | RAP380 | RAP460 | RAP540 | RAP620 | RAP700 | HU80 | HU120 | HU160 | rpd3Δ_1 | rpd3Δ_2 | rpd3Δ_3 |
|---|---|---|---|---|---|---|---|---|---|---|---|---|---|---|---|
| Cortical Patches | 0 | 0 | 0 | 0 | 0 | 0 | 0 | 0 | 0 | 0 | 0 | 0 | 0 | 0 | 0 |
| Bud | 0 | 0 | 0 | 0 | 0 | 0 | 0 | 0 | 0 | 0 | 0 | 0 | 0 | 0 | 0 |
| Bud Neck | 0 | 0 | 0 | 0 | 0 | 0 | 0 | 0 | 0 | 0 | 0 | 0 | 0 | 0 | 0 |
| Bud Site | 0 | 0 | 0 | 0 | 0 | 0 | 0 | 0 | 0 | 0 | 0 | 0 | 0 | 0 | 0 |
| Cell Periphery | 0 | 0 | 0 | 0 | 0 | 0 | 0 | 0 | 0 | 0 | 0 | 0 | 0 | 0 | 0 |
| Cytoplasm | 0.8 | -3.1 | -3.8 | -10.6 | -14.8 | -12.2 | -16.3 | -14.6 | -13.3 | 1.5 | 1.9 | -1.8 | 0.3 | -1.4 | -0.6 |
| Endoplasmic Reticulum | 0 | 0 | 0 | 0 | 0 | 0 | 0 | 0 | 0 | 0 | 0 | 0 | 0 | 0 | 0 |
| Endosome | 0 | 0 | 0 | 0 | 1.8 | 0 | 0 | 0 | 0 | 0 | 0 | 0 | 0 | 0 | 0 |
| Golgi | 2.2 | 2.1 | -1.2 | 0 | -1.0 | 0 | 0 | 0 | 0 | -0.5 | -0.4 | 1.6 | 0 | 0 | 0 |
| Mitochondria | 0 | 0 | 3.1 | 5.4 | 4.5 | 6.2 | 10.2 | 9.0 | 9.1 | 0 | 0 | 0 | 0 | 0 | 0 |
| Nucleus | 0 | 0 | 2.4 | 4.5 | 6.2 | 4.1 | 5.0 | 4.7 | 5.1 | 0 | 0 | 0 | 0 | 0 | 0 |
| Nuclear Periphery | 0 | 0 | 0 | 0 | 0 | 0 | 0 | 0 | 0 | 0 | 0 | 0 | 0 | 0 | 0 |
| Nucleolus | 0 | 0 | 0 | 0 | 0 | 0 | 0 | 0 | 0 | 0 | 0 | 0 | 0 | 0 | 0 |
| Peroxisomes | 0 | 0 | 0 | 0 | 0 | 0 | 0 | 0 | 0 | 0 | 0 | 0 | 0 | 0 | 0 |
| SpindlePole | 0 | 0 | 0 | 0 | 0 | 0 | 0 | 0 | 0 | 0 | 0 | 0 | 0 | 0 | 0 |
| Vacuole | -2.1 | 1.9 | 1.5 | 6.0 | 8.6 | 6.5 | 6.8 | 6.9 | 5.8 | -1.8 | -0.7 | 3.6 | 0.5 | 3.0 | 1.6 |
External localization resources
Images






























Protein Concentration and Protein Localization Data
| R1 | R2 | R3 | ||||||||||||||||
|---|---|---|---|---|---|---|---|---|---|---|---|---|---|---|---|---|---|---|
| G1 Pre-START | G1 Post-START | S/G2 | Metaphase | Anaphase | Telophase | G1 Pre-START | G1 Post-START | S/G2 | Metaphase | Anaphase | Telophase | G1 Pre-START | G1 Post-START | S/G2 | Metaphase | Anaphase | Telophase | |
| Concentration | 20.9947 | 25.5074 | 23.3569 | 24.4432 | 21.3429 | 22.2772 | 21.6715 | 30.512 | 25.8155 | 23.9864 | 24.0419 | 27.201 | 21.7567 | 30.5445 | 25.7637 | 21.6925 | 19.7714 | 24.9523 |
| Actin | 0.0002 | 0.0001 | 0.0018 | 0.0002 | 0.0001 | 0.0007 | 0.0119 | 0.0008 | 0.0034 | 0.0066 | 0.0005 | 0.0035 | 0.0053 | 0.0001 | 0.0198 | 0.0146 | 0.0508 | 0.0061 |
| Bud | 0.0001 | 0.0001 | 0.0002 | 0 | 0.0001 | 0.0002 | 0.001 | 0.0001 | 0.0009 | 0.001 | 0.0007 | 0.0001 | 0.0012 | 0.0001 | 0.0007 | 0.0004 | 0.0009 | 0.0002 |
| Bud Neck | 0.0002 | 0.0003 | 0.0006 | 0.0002 | 0.0003 | 0.001 | 0.0014 | 0.0003 | 0.0015 | 0.0017 | 0.0006 | 0.0006 | 0.0007 | 0.0002 | 0.0005 | 0.0014 | 0.0008 | 0.0005 |
| Bud Periphery | 0 | 0 | 0.0001 | 0 | 0.0001 | 0.0001 | 0.0008 | 0.0001 | 0.0008 | 0.0011 | 0.0005 | 0.0001 | 0.0015 | 0 | 0.0004 | 0.0004 | 0.0009 | 0.0001 |
| Bud Site | 0.0001 | 0.0001 | 0.0004 | 0 | 0.0002 | 0.0001 | 0.0031 | 0.0002 | 0.0012 | 0.0024 | 0.0004 | 0.0001 | 0.003 | 0 | 0.0007 | 0.0028 | 0.0026 | 0.0001 |
| Cell Periphery | 0 | 0.0001 | 0.0001 | 0 | 0.0001 | 0.0001 | 0.0006 | 0 | 0.0002 | 0.0004 | 0.0001 | 0 | 0.0002 | 0 | 0.0001 | 0.0001 | 0.0003 | 0.0001 |
| Cytoplasm | 0.598 | 0.7106 | 0.6792 | 0.6344 | 0.6053 | 0.6677 | 0.623 | 0.8043 | 0.6981 | 0.7163 | 0.7282 | 0.76 | 0.6479 | 0.8766 | 0.7425 | 0.6829 | 0.6958 | 0.6565 |
| Cytoplasmic Foci | 0.0018 | 0.0015 | 0.0047 | 0.0002 | 0.0041 | 0.0022 | 0.027 | 0.0007 | 0.0107 | 0.0117 | 0.0122 | 0.0022 | 0.0149 | 0.0002 | 0.0112 | 0.0294 | 0.0161 | 0.0034 |
| Eisosomes | 0 | 0 | 0 | 0 | 0 | 0 | 0.0002 | 0 | 0.0001 | 0.0004 | 0 | 0 | 0.0001 | 0 | 0.0002 | 0.0001 | 0.0003 | 0 |
| Endoplasmic Reticulum | 0.0037 | 0.0014 | 0.0025 | 0.0012 | 0.0036 | 0.0081 | 0.013 | 0.0008 | 0.0051 | 0.0043 | 0.0029 | 0.0023 | 0.0095 | 0.0003 | 0.0028 | 0.0004 | 0.0101 | 0.0035 |
| Endosome | 0.0035 | 0.0019 | 0.0057 | 0.0001 | 0.0154 | 0.0101 | 0.0225 | 0.0019 | 0.022 | 0.0259 | 0.0264 | 0.0068 | 0.0207 | 0.0002 | 0.0171 | 0.0145 | 0.0207 | 0.0104 |
| Golgi | 0.0001 | 0 | 0.0005 | 0 | 0.001 | 0.002 | 0.0085 | 0.0014 | 0.0034 | 0.0035 | 0.0031 | 0.0016 | 0.0041 | 0 | 0.0073 | 0.0151 | 0.0112 | 0.0031 |
| Lipid Particles | 0.0002 | 0.0003 | 0.0011 | 0 | 0.0031 | 0.0001 | 0.0041 | 0.0003 | 0.0101 | 0.0059 | 0.0024 | 0.0033 | 0.0114 | 0 | 0.0076 | 0.0184 | 0.0344 | 0.0016 |
| Mitochondria | 0.0003 | 0.0001 | 0.0003 | 0.0001 | 0.001 | 0.0011 | 0.0054 | 0.0012 | 0.0081 | 0.0163 | 0.0014 | 0.0024 | 0.0069 | 0.0001 | 0.0113 | 0.0672 | 0.0114 | 0.0015 |
| None | 0.0006 | 0.0001 | 0.0007 | 0.0001 | 0.001 | 0.0008 | 0.0032 | 0.0001 | 0.0011 | 0.0012 | 0.0007 | 0.0003 | 0.0023 | 0.0002 | 0.0018 | 0.0004 | 0.0045 | 0.0011 |
| Nuclear Periphery | 0.0751 | 0.0309 | 0.0454 | 0.0193 | 0.069 | 0.0551 | 0.048 | 0.0131 | 0.0272 | 0.0261 | 0.022 | 0.0298 | 0.0494 | 0.0082 | 0.0205 | 0.0091 | 0.0348 | 0.0447 |
| Nucleolus | 0.0003 | 0.0005 | 0.0012 | 0.0001 | 0.0002 | 0.0003 | 0.001 | 0.001 | 0.0016 | 0.0059 | 0.0003 | 0.0001 | 0.0011 | 0.0001 | 0.0005 | 0.0003 | 0.0005 | 0.0008 |
| Nucleus | 0.2986 | 0.2436 | 0.2381 | 0.3428 | 0.2832 | 0.2398 | 0.2011 | 0.1704 | 0.1828 | 0.1401 | 0.1672 | 0.1778 | 0.1994 | 0.1123 | 0.1335 | 0.0918 | 0.0735 | 0.2593 |
| Peroxisomes | 0 | 0 | 0.0014 | 0 | 0.0001 | 0 | 0.0035 | 0.0001 | 0.0016 | 0.0015 | 0.0008 | 0.0013 | 0.0021 | 0 | 0.0133 | 0.0445 | 0.0139 | 0.0002 |
| Punctate Nuclear | 0.0074 | 0.0006 | 0.0034 | 0.0005 | 0.0008 | 0.0018 | 0.0028 | 0.0004 | 0.0027 | 0.0044 | 0.0032 | 0.0012 | 0.003 | 0.0003 | 0.0029 | 0.0017 | 0.0034 | 0.0012 |
| Vacuole | 0.0075 | 0.0072 | 0.011 | 0.0005 | 0.009 | 0.0065 | 0.0141 | 0.0025 | 0.0126 | 0.0178 | 0.0183 | 0.0047 | 0.0108 | 0.0009 | 0.0036 | 0.0026 | 0.0098 | 0.0036 |
| Vacuole Periphery | 0.0022 | 0.0007 | 0.0017 | 0.0002 | 0.0024 | 0.0021 | 0.0038 | 0.0004 | 0.0048 | 0.0055 | 0.0081 | 0.0019 | 0.0044 | 0.0003 | 0.0019 | 0.0018 | 0.0035 | 0.0021 |
Sequencing Data
| R1 | R2 | |||||||||
|---|---|---|---|---|---|---|---|---|---|---|
| G1 Post-START | S/G2 | Metaphase | Anaphase | Telophase | G1 Post-START | S/G2 | Metaphase | Anaphase | Telophase | |
| Gene Expression | 166.3638 | 157.6168 | 120.7313 | 157.5538 | 146.8713 | 93.7943 | 146.2999 | 137.3432 | 111.2359 | 150.9904 |
| Translational Efficiency | 2.0193 | 2.2829 | 2.4011 | 1.5577 | 2.0651 | 3.2082 | 1.818 | 1.729 | 1.6798 | 1.7915 |
Hit Data
| Dataset | Hit |
|---|---|
| Protein Concentration | ✔ |
| Protein Localization | ✘ |
| Gene Expression | ✘ |
| Translational Efficiency | ✘ |
Endocytosis
| Temp | Actin Patch (Sac6-tdTomato) | Cortical Patch (Sla1-GFP) | Late Endosome (Snf7-GFP) | Vacuole (Vph1-GFP) |
|---|---|---|---|---|
| 37℃ | ||||
| RT |
Cell Cycle Omics
CYCLoPs (Map1-GFP)
| Gene / Allele | Actin Patch (Sac6-tdTomato) | Cortical Patch (Sla1-GFP) | Late Endosome (Snf7-GFP) | Vacuole (Sac6-tdTomato) |
|---|
| Gene | Images |
|---|
| Gene | Images |
|---|
Images are not yet available
Images are not yet available